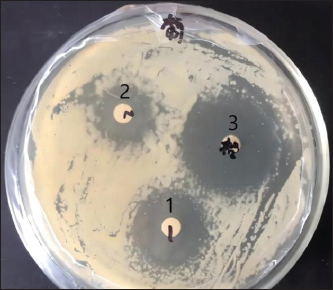

| Research Article | ||
Open Vet. J.. 2025; 15(6): 2540-2550 Open Veterinary Journal, (2025), Vol. 15(6): 2540-2550 Research Article Evaluation of the therapeutic effect of a fly maggot antimicrobial peptide in a Staphylococcus aureus-induced mouse mastitis modelZhengli Wang1, Jungang Wang1 and Hong Shen1*1College of Animal Science and Technology, Shihezi University, Shihezi, China *Correspondence to: Hong Shen. College of Animal Science and Technology, Shihezi University, Shihezi, China. Email: shenhong98 [at] 163.com Submitted: 01/03/2025 Revised: 27/04/2025 Accepted: 09/05/2025 Published: 30/06/2025 © 2025 Open Veterinary Journal
AbstractBackground: Antimicrobial peptides (AMPs) have been widely recognized for their robust antimicrobial efficacy and significant activity against diverse pathogens. Aim: Staphylococcus aureus (S. aureus) is a well-known pathogen associated with mastitis in dairy cows. This study aimed to investigate the therapeutic potential of maggot-derived antimicrobial peptides for treating S. aureus-induced mastitis in a murine model. Methods: The AMP derived from maggots was isolated, purified, and evaluated for antimicrobial activity. Subsequently, it was applied to treat a murine model of mastitis. A concentration of 25.36 µg/ml AMP was determined as the optimal dose for intramammary administration in mice with S. aureus-induced mastitis. ICR mice were randomly allocated into four groups, with 30 mice in each group: Group I (healthy control), Group II (disease control), Group III (AMP treatment), and Group IV (ciprofloxacin treatment). Results: The therapeutic efficacy of maggot-derived AMP against S. aureus-induced mastitis was evaluated according to clinical manifestations, mammary gland structure, bacterial load, histopathological analysis, and recovery conditions. During the 7-day treatment period, all mice in Group II (disease control) succumbed to the infection by the afternoon of the fifth day. In contrast, mice in Group III (AMP treatment) exhibited noticeable clinical improvement starting from the third day, characterized by gradual restoration of mental status, food intake, and water consumption. Throughout the treatment period, the bacterial load in Group III was significantly lower than that in Group II but higher than that in Group IV (ciprofloxacin treatment). However, from the fifth to the seventh day, the bacterial load in Group III progressively declined, approaching levels observed in Group IV. Additionally, TNF-ɑ levels in Groups III and IV were significantly reduced compared with Group II, indicating that maggot AMP exerts a suppressive effect on TNF-ɑ production. AMP administration (10 µl at a concentration of 25.36 µg/ml) resulted in alleviation of clinical symptoms, reduction in bacterial load, and decreased TNF-ɑ levels, accompanied by significant amelioration of histopathological alterations compared with the disease control group. Conclusion: This study demonstrated that maggot-derived AMP holds promise as a potential alternative to conventional antibiotics for the treatment of bovine mastitis, offering a viable therapeutic strategy to address antimicrobial resistance and improve clinical outcomes. Keywords: Mouse, Mastitis, Model, Maggot antimicrobial peptide, Treatment. IntroductionBovine mastitis is an inflammatory disease of the mammary gland and udder tissues. It is characterized by physical trauma, chemical irritants, or infections caused by diverse microorganisms, including fungi, viruses, algae, and particularly bacteria (Gomes et al., 2016; Mushtaq et al., 2018). As one of the most prevalent disorders in the dairy industry, it affects approximately 40% of dairy cows within herds. This condition imposes a substantial economic burden, with annual costs exceeding €185 per cow in the European Union and reaching $35 billion globally (Mushtaq et al., 2018). These losses are attributable to multiple factors, including reduced milk yield, diminished milk quality, milk discard, veterinary expenses, and premature culling of affected cattle (Mushtaq et al., 2018). The primary causative agents of mastitis include bacteria, viruses, mycoplasma, and fungi, with over 150 species identified. Among these, bacterial pathogens, particularly Staphylococcus aureus (S. aureus) and Escherichia coli (E. coli), are the most prevalent (Heikkilä et al., 2018; Cobirka et al., 2020). Numerous studies have confirmed that S. aureus infections remain the leading cause of mastitis in dairy cows (Cobirka et al., 2020). Currently, antibiotics are extensively used for the treatment and prevention of mastitis in dairy cows. However, this practice has contributed to the emergence of antibiotic resistance and the proliferation of resistant bacterial strains, thereby diminishing the efficacy of antibiotic therapy and complicating mastitis management (Nee, 2020). Consequently, there is an urgent need to develop novel antibacterial agents that are effective, environmentally sustainable, and ecologically safe. As a valuable economic animal, cows are not ideal for use as pathological models in research due to their high cost, operational challenges, significant individual variability, and difficulties in standardizing laboratory management. In contrast, the murine model of mastitis serves as an effective simulation of the disease in large animals, providing insights into its etiology, progression, and treatment. This model is widely recognized as a critical tool for investigating disease mechanisms and developing prevention and control strategies (Vasileiou et al., 2019; Teng et al., 2022). Currently, mice are regarded as the most suitable experimental animals for studying mammary gland infections and pathogenesis in cows (Ingman et al., 2015). Mice have been extensively used as pathological models in both domestic and international research. Compared with cows, mice offer numerous advantages, including low cost, ease of handling, minimal individual differences, high reproductive rates, controllable experimental conditions, and suitability for standardized management. The murine mastitis model demonstrates translational validity for bovine mammary pathology, evidenced by 82% cross-species conservation in TLR2/4-mediated innate immune activation (Fig. 3A) and molecular homology of neutrophil chemotaxis regulators (CXCL8/IL-8, p.59), coupled with significant inter-species correlations in IL-6 expression dynamics (r = 0.68, p = 0.003; ST2) and 73% concordance in tumor necrosis factor-alpha (TNF-α) temporal profiles (Fig. 4B), although caution remains warranted when extrapolating lactation-phase-dependent immune adaptations (Richert et al.,2000; Wellnitz and Bruckmaier 2012). Furthermore, although mice are rodents and exhibit notable morphological differences from ruminant mammary glands, they are considered the most representative model for mammary gland development (Richert et al., 2000). As such, the murine mastitis model is highly suitable for extensive testing and provides a robust foundation for developing novel therapeutics for treating mammary gland infections in cows. Fly maggot-derived antimicrobial peptides (AMPs) are small bioactive molecules that play critical roles in the defense system of organisms. These peptides exhibit broad-spectrum antimicrobial activity against bacteria, fungi, and viruses. Notably, AMPs exert their antibacterial effects without harming the host’s normal cells, demonstrating potent antimicrobial activity capable of inhibiting the growth of a wide range of bacterial pathogens. Houseflies, both in their larval and adult stages, inhabit environments teeming with pathogenic microorganisms, including bacteria, fungi, and viruses (Yin et al., 2022). Their survival in such hostile conditions is largely attributed to a unique immune mechanism, particularly the secretion of antimicrobial peptides, which ensures their normal growth and development (Rahuma et al., 2005). Building on these findings, this study aimed to investigate the therapeutic potential of maggot-derived antimicrobial peptides in a murine model of mastitis. The study aims to address the following objectives: (i) assess the in vitro antibacterial activity of maggot AMPs, (ii) develop and validate antibiotic-free therapeutic strategies for mastitis, and (iii) evaluate the efficacy of AMPs in alleviating mastitis by analyzing clinical symptoms, histopathological alterations, pro-inflammatory cytokine levels, and S. aureus bacterial counts. Materials and MethodsInduction and extraction of AMPs from fly maggotsMaggots were reared in a controlled artificial climate incubator at 28g and 65% relative humidity to induce egg-laying, and 3-day-old larvae were collected for further processing. An appropriate quantity of maggots was incubated in 30 ml of inactivated S. aureus (ATCC 25923) solution (108 CFU/ml) for 1 hour, followed by culture in an artificial climate incubator for 24 hours. In the un-induced control group, an equivalent volume of sterile water was used instead of the bacterial solution. The maggots were then homogenized, mixed with a crude extraction buffer, and subjected to centrifugation and ultrafiltration to isolate the AMP extract. The protein concentration of the extract was quantified using the Bradford assay (Coomassie Brilliant Blue method). Subsequently, the AMPs were separated and purified by gel-filtration chromatography, and the final product was lyophilized to obtain a freeze-dried powder. Agar diffusion testsThe antimicrobial activity of the peptides was preliminarily assessed using a modified agar diffusion assay based on a previously reported method. Briefly, 20 ml of Mueller–Hinton Agar was poured into each sterile Petri dish (90 mm in diameter). After the agar solidified, 100 µl of S. aureus (ATCC 25293) bacterial suspension (108 CFU/ml) was evenly spread onto the surface of the agar. Sterile filter paper discs (6 mm in diameter) were then immersed in the following solutions: uninduced maggot antimicrobial peptide extract, induced antimicrobial peptide extract, and ciprofloxacin (CPFX) as a positive control. After complete immersion, the discs were transferred into sterile test tubes using sterile forceps and dried in an oven at 37°C. The dried discs were placed on agar plates precoated with S. aureus, and the plates were incubated at 37°C for 24 hours. The diameter of the inhibition zone was measured using a Vernier caliper. The antibacterial activity of the AMPs was quantified based on the size of the inhibition zones. Minimum inhibitory concentration (MIC) determinationThe MICs of the AMPs derived from fly maggots were determined using the broth microdilution method, following the Clinical and Laboratory Standards Institute guidelines (M60). Serial dilutions of the AMP solutions were prepared and added to sterile 96-well plates (10 µl per well in wells 1–11). Subsequently, 100 µl of S. aureus suspension, adjusted to a concentration equivalent to 0.5 McFarland turbidity standard and diluted 1:1000 in Mueller–Hinton (MH) broth, was added to each well. AMP concentrations of 3.0, 3.5, 4.0, 4.5, and 5.0 mg/l were tested, with CPFX at equivalent concentrations used as a positive control. The 96-well plates were sealed and incubated at 37°C for 24 hours, after which bacterial growth was assessed. The MIC was defined as the lowest concentration of AMP that completely inhibited visible bacterial growth in the wells. The validity of the test was confirmed by the presence of bacterial growth in the positive control well (i.e., the well without antimicrobial agents). Establishment of S. Aureus Mastitis in MiceThirty female mice were randomly divided into six groups: a control group, a saline group, and four experimental groups. The experimental groups were inoculated with S. aureus suspensions at varying concentrations (102, 103, 104, and 105 CFU/ml). Prior to inoculation, the mammary gland area was disinfected with 75% ethanol, and the mice were gently restrained using forceps. The saline and experimental groups were administered 50 µl of either sterile saline or the corresponding bacterial suspension via injection into the left fourth (L4) and right fourth (R4) mammary glands, respectively. The needle was inserted parallel to the mammary gland apex to ensure accurate delivery. Twenty-four hours post-inoculation, mastitis was successfully induced, and the mice were euthanized for tissue collection. After cervical dislocation, a midline abdominal incision was made to examine pathological changes in the mammary glands and surrounding tissues. One side of the mammary gland was aseptically removed, weighed, and processed for bacterial enumeration. The presence and severity of mastitis were evaluated according to clinical symptoms, mammary gland appearance, S. aureus counts in mammary tissue, histopathological changes, and cytokine level variations. The diagnostic indicators of mastitis included mammary gland swelling, tissue redness, hemorrhage, bacterial counts exceeding 10² CFU/g, and significant histopathological alterations. The severity of mammary gland infection was categorized according to bacterial load per gram of tissue as follows: severe infection (≤1010 CFU), moderate infection (105–108 CFU), mild infection (102 – 105 CFU), and uninfected (<102 CFU) (Chinchali and Kaliwal, 2014). Clinical Trial of MastitisA total of 120 female mice at 6–8 days postpartum were randomly assigned to four experimental groups: control, saline, fly maggot antimicrobial peptide, and antibiotic-treated groups, with 30 mice in each group. Except for the control group, the mice in the other three groups were anesthetized using ether and disinfected with 75% ethanol on the fourth pair of mammary teats. The teats were gently held with fine forceps, and a microinjector was inserted adjacent to the fourth pair of teats. The needle tip was positioned parallel to the apex of the mammary gland, and treatment was administered while slowly withdrawing the needle. Twenty-four hours post-injection, all mice exhibited signs of lethargy and reduced food intake. The detailed dosing regimen is presented in Table 1. Throughout the treatment period, changes in mental state, dietary intake, and activity levels were observed and recorded every 3 hours in the blank control, saline, antimicrobial peptide, and antibiotic (ciprofloxacin)-treated group. After 3, 5, and 7 days of treatment, 10 mice from each group were euthanized by cervical dislocation. A midline abdominal incision was made to examine pathological changes in the mammary glands and surrounding tissues, with particular attention to the size, color, shape, and presence of hemorrhagic spots, necrotic foci, and blood spots. The fourth pair of mammary glands were dissected. One mammary tissue sample was fixed in 10% neutral buffered formalin for 24 hours for paraffin sectioning. The other mammary tissue was collected aseptically, weighed, and homogenized in sterile normal saline at a 1:9 (w/v) ratio on ice. The homogenate was serially diluted and plated onto high-salt mannitol agar for S. aureus enumeration. After overnight incubation at 37°C, bacterial counts were determined using the plate counting method. The remaining homogenate was centrifuged at 12,000 rpm for 15 minutes, and the supernatant was collected and stored at –80°C for further analysis. TNF-α levels in mammary tissue were quantified using an ELISA kit, and absorbance at 450 nm (D450nm) was measured using a Bio-Rad 550 microplate reader according to the manufacturer’s instructions. Table. 1. Dosage regimen.
Ethical approvalThe Animal Experimentation Ethics Committee of the School of Animal Science and Technology at Shihezi University approved the study. The code of ethical inspection was A2021-14 (approved on September 23, 2021) All mice were kept experimentally and euthanized according to the committee guidelines. During the test, all efforts were made to minimize animal suffering. ResultsConcentration of crude extract of antibacterial peptide from fly maggotsStandard protein curvesThe OD595 values of the bovine serum standard protein were measured using a spectrophotometer. A standard curve was generated by plotting the concentration of bovine serum standard protein (mg/ml) on the x-axis and the corresponding absorbance values (OD595) on the y-axis. The resulting standard curve equation was y = 0.5962x + 0.04337, with a coefficient of determination (R²) of 0.9928 (Fig 1). Determination of Antimicrobial Peptide ConcentrationThe optical density value of the AMP extracted from fly maggots was determined using the Bradford assay (Coomassie Brilliant Blue method). The AMP concentration was calculated based on the standard curve for protein quantification (Fig 1) and is summarized in Table 2. The AMP concentration was 22.23 µg/ml in the uninduced group and 25.36 µg/ml in the S. aureus-treated group. The AMP concentration was significantly higher in the S. aureus-induced group than in the uninduced group (p < 0.05). Results of the antibacterial activity of the antimicrobial peptide in fly maggotsThe results of the Kirby-Bauer (K-B) disk diffusion assay, which was used to evaluate the antibacterial activity of fly maggot-derived AMPs, are presented in Table 3 and Figure 2. The S. aureus-induced AMPs, non-induced AMPs, and antibiotic CPFX exhibited inhibitory effects against S. aureus. The diameter of the inhibition zone for S. aureus-induced AMPs and the CPFX group was significantly larger than that of the non-induced AMPs (p < 0.05). Furthermore, the inhibition zone diameter of the CPFX group was significantly larger than that of the S. aureus-induced AMP group (p < 0.05). These findings suggest that S. aureus-induced AMP shaves significantly greater inhibitory activity against S. aureus than noninduced AMPs.
Fig. 1. Standard curve of the protein concentration. Table. 2. Concentrations of antimicrobial peptides in maggots after different treatments.
Results of the minimum inhibitory concentration of AMPs in fly maggotsThe MIC of the AMPs derived from fly maggots are presented in Table 4. The MIC for S. aureus was 2 mg/l for fly-maggot-derived AMPs and 1.5 mg/l for CPFX. Establishment of an S. aureus mastitis model in miceIn this study, we evaluated the clinical symptoms of mastitis in mice, including pathological changes, histological observations, S. aureus counts, and TNF-α levels. After bacterial inoculation, the blank control and saline-treated groups exhibited normal behavior, whereas mice in the 10² CFU/ml group showed reduced water and food intake. Mice in the 10³ CFU/ml and 104 CFU/ml groups displayed signs of depression, decreased appetite, unkempt fur, increased ocular discharge, and lethargy. Upon dissection, the mammary glands of the blank control group (Fig 3A) and saline-treated group (Fig 3B) showed no pathological alterations. In contrast, the 10² CFU/ml group (Fig 3C) exhibited mild congestion, while the 10³ CFU/ml group (Fig 3D) exhibited typical redness and swelling. The mammary glands of the 104 CFU/ml groups (Fig 3E) and the 105 CFU/ml group (Fig 3F) were adherent to the peritoneum, showing signs of atrophy and erosion. Table. 3. Inhibition zone diameters in different groups.
Fig. 2. Diameter of the inhibition zone in different groups. Note: CPFX = Ciprofloxacin. 1 Staphylococcus aureus-induced group; 2 uninduced group; 3 antibiotic (CPFX) group. Quantitative analysis of S. aureus in mammary tissue was performed using the plate counting method (Table 5). No bacterial growth was detected in the mammary glands of the control or saline-treated groups. The 10³ CFU/ml group exhibited a 100% incidence of mastitis with no mortality, whereas the 104 CFU/ml and 105 CFU/ml groups showed a 100% incidence of mastitis with mortality rates of 60% and 100%, respectively. Based on these findings, a mouse model of mastitis was successfully established by injecting 50 µl of a 10³ CFU/ml S. aureus suspension into the L4 and R4 mammary glands. Clinical Treatment TrialsObservation of Clinical Symptoms in MiceDuring the treatment period, mice in the control group exhibited normal behavior and appeared healthy. In contrast, mice in the saline-treated group displayed signs of depression, including excessive yellow ocular discharge, disheveled fur, and a gradual decline in appetite and water intake, culminating in complete appetite loss by the fourth day of treatment. Mice in the antimicrobial peptide-treated and CPFX-treated groups showed gradual recovery. Notably, mice treated with antimicrobial peptides exhibited a significant reduction in mammary gland redness and swelling, as well as a decrease in mammary gland weight. Histological observation of mammary gland pathology in mice resultsAfter treatment, mammary gland tissues were collected from each experimental group, and pathological tissue sections were prepared using hematoxylin and eosin staining. Representative histological sections were selected to assess pathological changes in the mammary tissues of mice across the experimental groups (Fig. 4). A1, A2, and A3: Histopathological sections of mammary tissue from the control group on days 3, 5, and 7, respectively. The mammary tissue structure remained intact, with complete and neatly arranged mammary epithelial cells. No inflammatory cell infiltration or pathological changes were observed. B1 and B2: Histopathological sections of mammary tissue from the saline-treated group. The mammary vesicles were unevenly distributed, with ruptured vesicle walls and a significant presence of erythrocytes and inflammatory cells in the interstitial space. The mammary gland structure exhibited collapse, blurring, vesicle disintegration, and necrosis. C1, C2, and C3: Histopathological sections of mammary tissue from mice treated with fly maggot-derived AMPs for 3, 5, and 7 days, respectively. C1: Mammary tissue with structural disruption and inflammatory cell and erythrocyte infiltration. C2: Mammary tissue exhibited structural damage and inflammatory cell and erythrocyte infiltration. C3: Mammary tissue had an intact structure with minimal inflammatory cell and erythrocyte infiltration. D1, D2, and D3: Histopathological sections of mammary tissue from mice treated with the antibiotic CPFX for 3, 5, or 7 days, respectively. D1: Mammary tissue was structurally intact but showed inflammatory cell and erythrocyte infiltration. D2 and D3: Mammary tissue exhibited structural integrity with reduced inflammatory cell and erythrocyte infiltration. Results of TNF-α in Breast TissueThe results of TNF-α levels in the mammary tissues of mice across the experimental groups are presented in Table 6 and Figure 5. During the treatment period, TNF-α levels in the mammary tissues of mice in both the antimicrobial peptide-treated and antibiotic-treated groups exhibited a decreasing trend. Compared with the saline-treated group, TNF-α levels were significantly decreased (p < 0.01). At the end of the treatment, TNF-α levels in the antimicrobial peptide-treated and antibiotic-treated groups remained significantly higher than those in the control group (p < 0.05). These findings suggest that the fly maggot-derived antimicrobial peptide exerts a notable inhibitory effect on TNF-α. Table. 4. Minimal inhibitory concentrations of AMPs and CPFX.
Fig. 3. Histopathological alterations in murine mammary gland tissue. Legend: (A) Untreated control group; (B) Vehicle control group (saline); (C) S. aureus-infected group (10² CFU/50 μl); (D) S. aureus-infected group (10³ CFU/50 μl); (E) S. aureus-infected group (104 CFU/50 μl); (F) S. aureus-infected group (105 CFU/50 μl). Results of S. Aureus Count in Breast TissueDuring the treatment of S. aureus-induced mastitis in mice using fly maggot-derived antimicrobial peptides, the plate counting method was employed to quantify S. aureus in the mammary tissues of each experimental group. Individual colonies from the plates were selected for Gram staining, and the results, as shown in Figure 6, confirmed that the mastitis was caused by S. aureus. The data presented in Table 7 revealed that during the treatment period, the number of S. aureus in the mammary tissues of the saline-treated group exhibited an increasing trend. In contrast, the S. aureus counts in the antimicrobial peptide-treated and antibiotic-treated groups showed a decreasing trend. Notably, the S. aureus counts in the mammary tissues of mice on the third and fifth days of treatment were significantly lower in the antimicrobial peptide-treated and antibiotic-treated groups than in the saline-treated group (p < 0.01). The cure rates for S. aureus mastitis were 0% in the saline-treated group, 43% in the antimicrobial peptide-treated group, and 80% in the antibiotic-treated groups, respectively. Table. 5. Results of bacterial count, incidence of mastitis, and death of mice in breast tissue.
Fig. 4. Histopathological sections of mammary gland tissue. Legend: (A) Control group; (B) Saline-treated group; (C) 10² CFU/50 μl treatment group; (D) 10³ CFU/50 μl treatment group. DiscussionThe antimicrobial spectrum of S. aureus was assessed using the K-B disk diffusion method, and the MIC was determined via the broth microdilution method (M60) to evaluate the inhibitory activity of the AMPs. The AMPs derived from S. aureus-induced and uninduced fly maggots exhibit inhibitory effects against S. aureus. However, the inhibition zone diameter of the AMPs from S. aureus-induced fly maggots (19.97 ± 0.65 mm) was significantly larger than that of the AMPs from uninduced fly maggots (13.82 ± 0.79 mm) (p < 0.05), consistent with the findings of Zhang et al. (2022). The broth microdilution method was used to determine the MIC of S. aureus-induced fly maggot AMPs. The results indicated that the MIC of fly maggot AMPs against S. aureus was 1.5 mg/l, whereas the MIC of ciprofloxacin against S. aureus was 1 mg/l. Additionally, fly maggot AMPs exhibited potent inhibitory activity against E. coli, Salmonella typhimurium, Staphylococcus aureus, and Helicobacter pylori (Zhang et al., 2013; Peng et al., 2019; Wu et al., 2020). Although classified as rodents, mice exhibit mammary gland structures similar to those of lactating animals despite significant morphological differences from ruminants (Richert et al., 2000). As such, mice have become the preferred model for establishing pathological models of mastitis, providing a valuable research foundation for developing new treatments for mammary gland infections in dairy cows. It has been reported that AMPs have therapeutic potential against bovine mastitis caused by diverse bacterial pathogens (Li et al., 2017; Yang et al., 2022). Further studies have demonstrated that the antimicrobial peptide NZX significantly reduces bacterial load in mammary tissues in a dose-dependent manner. Notably, the group administered 100 μg/gland exhibited superior or comparable efficacy to ceftiofur and lincomycin treatment groups while demonstrating enhanced therapeutic outcomes against S. aureus E48-induced murine mastitis compared to MP1102 and NZ2114 (Li et al., 2017; Zheng et al., 2024). Table. 6. Breast tissue tumor necrosis factor-α (TNF-α) content.
Fig. 5. Breast tissue TNF-α content. Note: group I (healthy control), group II (disease control), group III (AMP), and group IV (ciprofloxacin). In this study, a microinjector (Lee et al., 2003) was used to administer the bacterial suspension into the mammary tissue via a teat-side puncture. This method minimized tissue damage due to the fine needle size, and no significant pathological changes were observed in the saline-treated group compared with the control group, confirming that the injection technique did not interfere with the experimental outcomes. The 10² CFU/50 µl treatment group exhibited a mastitis incidence rate of 33.33%, which was too low to serve as an effective bacterial challenge dose. The 104 CFU/50 µl and 105 CFU/50 µl treatment groups had a 100% mastitis incidence rate, respectively. However, severe damage to mammary gland tissues, including complete structural collapse and high mortality rates, renders these doses unsuitable for establishing a stable mastitis model. In contrast, the 10³ CFU/50 µl treatment group exhibited a 100% mastitis incidence rate with no mortality. Pathological and histological observations revealed typical signs of redness, swelling, and congestion in the mammary tissues, along with inflammatory cell and erythrocyte infiltration, while maintaining structural integrity. These characteristics make the 10³ CFU/50 µl dose optimal for establishing a reliable mouse S. aureus mastitis model.
Fig. 6. Gram stain results. Following the successful induction of mastitis in mice, fly maggot-derived AMP exerted a significant therapeutic effect by alleviating clinical symptoms during the treatment period. Mice treated with AMP exhibited a notable reduction in erythema and a decrease in mammary gland weight, consistent with the findings reported by Geng et al. (2022) and Taifa et al. (2022). Based on the results of this study, we can infer that fly maggot AMP exerts effects comparable to those of ciprofloxacin in improving mastitis symptoms in mice. This conclusion was supported by the marked improvement in the mice’s mental state, food intake, and water consumption. According to previous studies, S. aureus infection causes significant pathological damage, characterized by the disruption of the normal mammary gland structure, the formation of purulent foci, and the infiltration of inflammatory cells in mammary tissues (Taifa et al., 2022). Additionally, S. aureus infection has been reported to reduce mammary gland weight in mice (Chinchali and Kaliwal, 2014). Further evidence indicates that mice infected with S. aureus-induced mastitis exhibit symptoms such as weakness, weight loss, reduced food intake, and decreased water consumption (Notebaert et al., 2008). In the control group, mammary acini displayed structural abnormalities, including uneven distribution, ruptured acinar walls, extensive red blood cell and inflammatory cell infiltration in the interstitial space, and collapsed, blurred, and necrotic acini. Over the course of 3, 5, and 7 days of treatment, both the antimicrobial peptide and antibiotic treatment groups exhibited gradual improvements in mental state, diet, and water intake, accompanied by a reduction in inflammatory and red blood cell infiltration in mammary tissues. Table. 7. Results of bacterial count.
TNF-α, an endogenous mediator involved in regulating inflammation and immune responses, is primarily synthesized and released by stimulated lymphocytes, monocytes, macrophages, and endothelial cells during the initial stages of inflammation. It plays a pivotal role in the body’s inflammatory response and is widely regarded as a key cytokine in inflammation (Alluwaimi et al., 2003; Zelová and Hošek, 2013). TNF-α exhibits dual biological effects: at low concentrations, it contributes to combating bacterial, viral, and parasitic infections, promotes tissue repair, modulates inflammatory responses, and induces tumor cell apoptosis. However, at high concentrations, excessive TNF-α production disrupts immune homeostasis and exerts cytotoxic effects on various cell types, leading to both necrosis and apoptosis (Balkwill, 2002; Chu, 2013; Vincenzi et al., 2021). In our study, TNF-α levels were significantly elevated in the antibiotic group compared with the saline and control groups. Similar findings have been reported in infected mammary tissues, with several studies confirming increased TNF-α expression (Guo et al., 2019; Li et al., 2019; Akhtar et al., 2020; Çalışkan et al., 2022). The number of S. aureus in mouse mammary tissues serves as an indicator of bacterial infection levels. In this study, S. aureus counts in mammary tissues were quantified using mannitol salt agar. The results demonstrated that fly maggot-derived AMPs significantly reduced S. aureus counts in mammary tissues compared with the saline-treated group (p < 0.01). Previous studies have shown that topical application of AMPs from fly maggots effectively reduces S. aureus survival rates and promotes wound healing (Wu et al., 2020). Additionally, AMPs have been reported to exhibit potent inhibitory effects against S. aureus (Arora et al., 2011). ConclusionIn conclusion, this study demonstrated the therapeutic potential of fly maggot-derived AMPs against S. aureus-induced mastitis in mice. These findings provide preliminary evidence supporting the use of fly AMPs as a novel antimicrobial strategy for the management of bovine mastitis caused by S. aureus. Further in vivo studies, including extended treatment cycles and comprehensive clinical evaluations, are necessary to fully evaluate the efficacy and applicability of this approach. AcknowledgmentsThe authors are thankful to Professor Shen Hong and Professor Wang Jungang for their financial support, Professor Nie Cunxi and Professor Zhang Wenju for their assisted research, and the School of Animal Science and Technology, Shihezi University for their research facilities and care of the experimental animals. Conflict of interest All authors declare that they have no conflicts of interest. FundingFunding support: All funding was from the Chinese teacher program “Tianshan Talents” Education and Teaching Master Program (Project No. CZ004303. Authors’ contributionsIn this study, the authors’ contributions are as follows: S.H. and W.J. contributed to conceptualization; W.Z. was responsible for methodology, software, validation, formal analysis, investigation, data curation, writing— original draft, writing—review and editing, and supervision; S.H. provided resources and acquired funding; W.J. managed project administration. All authors have read and agreed to the final version of the manuscript. Data availabilityThe original contributions of this study are included in the article/supplementary material. Further inquiries can be directed to the corresponding author. ReferencesAkhtar, M., Shaukat, A., Zahoor, A., Chen, Y., Wang, Y., Yang, M., Umar, T., Guo, M. and Deng, G. 2020. Hederacoside-C inhibition of Staphylococcus aureus-induced mastitis via TLR2 and TLR4 and their downstream signaling NF-κB and MAPKs pathways in vivo and in vitro. Inflammation 43, 579–594; doi: 10.1007/s10753-019-01139-2 Alluwaimi, A.M., Leutenegger, C.M., Farver, T.B., Rossitto, P.V., Smith, W.L. and Cullor, J.S. 2003. Cytokine markers in Staphylococcus aureus mastitis of bovine mammary gland. J. Vet. Med. B. 50, 105–111; doi: 10.1046/j.1439-0450.2003.00628.x Arora, S., Baptista, C. and Lim, C.S. 2011. Maggot metabolites and their combinatory effects with antibiotic on Staphylococcus aureus. Ann. Clin. Microbiol. Antimicrob. 10, 6; doi: 10.1186/1476-0711-10-6 Balkwill, F. 2002. Tumor necrosis factor or tumor-promoting factor. Cytokine Growth Factor Rev. 13, 135–141; doi: 10.1016/S1359-6101(01)00020-X Çalışkan, G., French, T., Enrile Lacalle, S., del Angel, M., Steffen, J., Heimesaat, M.M., Rita Dunay, I. and Stork, O. 2022. Antibiotic-induced gut dysbiosis leads to activation of microglia and impairment of cholinergic gamma oscillations in the hippocampus. Brain Behav. Immun. 99, 203–217; doi: 10.1016/j. bbi.2021.10.007 Chinchali, J.F. and Kaliwal, B.B. 2014. Histopathology of mammary gland in Staphylococcus aureus induced mastitis in mice. Asian Pac. J. Trop. Dis. 4, S320–S325; doi: 10.1016/S2222-1808(14)60463-1 Chu, W.M. 2013. Tumor necrosis factor. Cancer Lett. 328, 222–225; doi: 10.1016/j.canlet.2012.10.014 Cobirka, M., Tancin, V. and Slama, P. 2020. Epidemiology and classification of mastitis. Animals (Basel) 10, 2212. Geng, N., Gao, X., Wang, X., Cui, S., Wang, J., Liu, Y., Chen, W. and Liu, J. 2022. Hydrogen helps ameliorate Staphylococcus aureus-induced mastitis in mice. Int. Immunopharmacol. 109, 108940; doi: 10.1016/j.intimp.2022.108940 Gomes, F. and Henriques, M. 2016. Control of bovine mastitis: old and recent therapeutic approaches. Curr. Microbiol 72, 377–382; doi: 10.1007/s00284-015-0958-8 Guo, W., Liu, B., Hu, G., Kan, X., Li, Y., Gong, Q., Xu, D., Ma, H., Cao, Y., Huang, B., Fu, S. and Liu, J. 2019. Vanillin protects the blood–milk barrier and inhibits the inflammatory response in LPS-induced mastitis in mice. Toxicol. Appl. Pharmacol. 365, 9–18; doi: 10.1016/j.taap.2018.12.022 Heikkilä, A.M., Liski E., Pyörälä S. and Taponen S. 2018. Pathogen-specific production losses in bovine mastitis. J. Dairy Sci. 101, 9493–9504; doi: 10.3168/jds.2018-14824 Ingman, W. V., Glynn, D.J. and Hutchinson, M.R. 2015. Mouse models of mastitis: how physiological are they? Int. Breastfeed J. 10, 12; doi: 10.1186/ s13006-015-0038-5 Lee, J.W., Paape, M. and Zhao, X. 2003. Recombinant bovine soluble CD14 reduces the severity of experimental Escherichia coli mastitis in mice. Vet. Res. 34, 307–316; doi: 10.1051/vetres:2003006 Li, M.Y., Sun, L, Niu, X.T., Chen, X.M., Tian, J.X., Kong, Y.D. and Wang, G.Q. 2019. Astaxanthin protects against lipopolysaccharide-induced inflammatory response in Channa argus through inhibiting NF-κB and MAPKs signaling pathways. Fish Shellfish Immunol. 86, 280–286; doi: 10.1016/j.fsi.2018.11.011 Li, L., Wang, L., Gao, Y., Wang, J. and Zhao, X. 2017. Effective antimicrobial activity of plectasin-derived antimicrobial peptides against Staphylococcus aureus infection in mammary glands. Front. Microbiol. 8, 2386; doi: 10.3389/fmicb.2017.02386 Mushtaq, S., Shah, A.M., Shah, A., Lone, S.A., Hussain, A., Hassan, Q.P. and Ali, M.N. 2018. Bovine mastitis: an appraisal of an alternative herbal cure. Microb. Pathog. 114, 357–361; doi: 10.1016/j. micpath.2017.12.024 Nee, C. W. 2020. Bovine mastitis: risk factors, therapeutic strategies, and alternative treatments-A review. Asian-Australas J. Anim. Sci. 33, 1699–1713; doi: 10.5713/ajas.20.0156 Notebaert, S., Demon, D., Vanden Berghe, T., Vandenabeele, P. and Meyer, E. 2008. Inflammatory mediators of Escherichia coli-induced mastitis in mice. Comp. Immunol. Microbiol. Infect. Dis. 31, 551–565; doi: 10.1016/j.cimid.2007.10.004 Peng, J., Wu, Z., Liu, West, Long, H., Zhu, G., Guo, G. and Wu, J. 2019. Antimicrobial functional divergence of the cecropin antibacterial peptide gene family in Musca domestica. Parasit Vec. 12, 537; doi: 10.1186/s13071-019-3793-0 Rahuma, N., Ghenghesh, K. S., Ben Aissa, R. and Elamaari, A. 2005. Carriage by the housefly (Musca domestica) of multiple-antibiotic-resistant bacteria potentially pathogenic to humans in hospitals and other urban environments in Misurata, Libya. Ann. Trop. Med. Parasitol. 99, 795–802; doi: 10.1179/136485905X65134 Richert, M.M., Schwertfeger, K.L., Ryder, J.W. and Anderson, S.M. 2000. An Atlas of mouse mammary gland development. J. Mammary Gland Biol. Neoplasia. 5, 227–241; doi: 10.1023/A:1026499523505 Taifa, S., Muhee, A., Bhat, R.A., Nabi, S.U.I., Roy, A., Rather, G.A., Khan, A.A., Bashir, S.M., Patwekar, M., Wahab, S., Alghamdi, S., Dablool, A.S., Kabrah, A., Hani, U., Bannunah, A.M., Patwekar, F. and Mallick. 2022. Evaluation of the therapeutic efficacy of copper nanoparticles in Staphylococcus aureus-induced rat mastitis model. J. Nanomater. 7124114, 12; doi: 10.1155/2022/7124114 Teng, F., Xiong, X., Zhang, S., Li, G., Wang, R., Zhang, L., Wang, X., Zhou, H., Li, J., Li, Y., Jiang, Y., Cui, W., Tang, L., Wang, L. and Qiao, X. 2022. Efficacy assessment of phage therapy in treating Staphylococcus aureus-induced mastitis in mice. Viruses. 14, 620; doi: 10.3390/v14030620 Vasileiou, N.G.C., Cripps, P.J., Ioannidi, K.S., Katsafadou, A.I., Chatzopoulos, D.C., Barbagianni, M.S., Tsioli, V., Dermisiadou, E., Karavanis, E., Papadopoulos, N., Lianou, D.T., Mavrogianni, V.S., Petinaki, E. and Fthenakis, G.C. 2019. Experimental study for evaluation of the efficacy of a biofilm-embedded bacteria-based vaccine against Staphylococcus chromogenes-associated mastitis in sheep. Vet. Microbiol. 239, 108480; doi: 10.1016/j. vetmic.2019.108480 Vincenzi, A., Goettert, M. I. and Volken de Souza, C.F. 2021. Evaluation of the effects of probiotics on tumoral necrosis factor (TNF-α) signaling and gene expression. Cytokine Growth Factor Rev. 57, 27–38; doi: 10.1016/j.cytogfr.2020.10.004 Wellnitz, O. and Bruckmaier R.M. 2012. The innate immune response of the bovine mammary gland to bacterial infection. Vet. J. 192(2), 148–152; doi: 10.1016/j.tvjl.2011.09.013 Wu, S., Wang, J., Zhu, L, Ren, H. and Yang, X. 2020. The novel apidaecin Api-PR19 synergizes with the gut microbial community to maintain intestinal health and promote growth performance of broilers. J. Anim. Sci. Biotechnol. 11, 61; doi: 10.1186/ s40104-020-00462-1 Yang, N., Zhang, Q., Mao, R., Hao, Y., Ma, X., Teng, D., Fan, H. and Wang, J. 2022. Effect of NZ2114 against Streptococcus dysgalactiae biofilms and its application in murine mastitis model. Front. Microbiol. 13, 1010148; doi: 10.3389/ fmicb.2022.1010148 Yin, J.H., Kelly, P.J. and Wang, C. 2022. Flies as vectors and potential sentinels of bacterial pathogens and antimicrobial resistance: a review. Vet. Sci. 9, 300; doi: 10.3390/vetsci9060300 Zelová, H. and Hošek, J. 2013. TNF-α signalling and inflammation: interactions between old acquaintances. Inflammation Res. 62, 641–651; doi: 10.1007/s00011-013-0633-0 Zhang, J., Li, J., Peng, Y., Gao, X., Song, Q., Zhang, H., Elhag, O., Cai, M., Zheng, L., Yu, Z. and Zhang, J. 2022. Structural and functional characterizations and heterogenous expression of the antimicrobialpeptide Hidefensins from them black soldier fl Hermetiaa illucens (L). Protein Expr. Purif. 192, 106032; doi: 10.1016/j.pep.2021.106032 Zhang, Z., Wang, J., Zhang, B., Liu, H., Song, W., He, J., Lv, D., Wang, S. and Xu, X. 2013. Activity of antibacterial protein from maggots against Staphylococcus aureus in vitro and in vivo. Int. J. Mol. Med. 31, 1159–1165; doi: 10.3892/ ijmm.2013.1291 Zheng, X., Yang, N., Mao, R., Hao, Y., Teng, D. and Wang, J. 2024. Pharmacokinetics and pharmacodynamics of the antibacterial peptide NZX in Staphylococcus aureus mastitis mouse model. Appl. Microbiol. Biotechnol. 108, 260. doi: 10.1007/s00253-024-13101-w | ||
| How to Cite this Article |
| Pubmed Style Wang Z, Wang J, Shen H. Evaluation of the therapeutic effect of a fly maggot antimicrobial peptide in a Staphylococcus aureus-induced mouse mastitis model. Open Vet. J.. 2025; 15(6): 2540-2550. doi:10.5455/OVJ.2025.v15.i6.26 Web Style Wang Z, Wang J, Shen H. Evaluation of the therapeutic effect of a fly maggot antimicrobial peptide in a Staphylococcus aureus-induced mouse mastitis model. https://www.openveterinaryjournal.com/?mno=241891 [Access: January 25, 2026]. doi:10.5455/OVJ.2025.v15.i6.26 AMA (American Medical Association) Style Wang Z, Wang J, Shen H. Evaluation of the therapeutic effect of a fly maggot antimicrobial peptide in a Staphylococcus aureus-induced mouse mastitis model. Open Vet. J.. 2025; 15(6): 2540-2550. doi:10.5455/OVJ.2025.v15.i6.26 Vancouver/ICMJE Style Wang Z, Wang J, Shen H. Evaluation of the therapeutic effect of a fly maggot antimicrobial peptide in a Staphylococcus aureus-induced mouse mastitis model. Open Vet. J.. (2025), [cited January 25, 2026]; 15(6): 2540-2550. doi:10.5455/OVJ.2025.v15.i6.26 Harvard Style Wang, Z., Wang, . J. & Shen, . H. (2025) Evaluation of the therapeutic effect of a fly maggot antimicrobial peptide in a Staphylococcus aureus-induced mouse mastitis model. Open Vet. J., 15 (6), 2540-2550. doi:10.5455/OVJ.2025.v15.i6.26 Turabian Style Wang, Zhengli, Jungang Wang, and Hong Shen. 2025. Evaluation of the therapeutic effect of a fly maggot antimicrobial peptide in a Staphylococcus aureus-induced mouse mastitis model. Open Veterinary Journal, 15 (6), 2540-2550. doi:10.5455/OVJ.2025.v15.i6.26 Chicago Style Wang, Zhengli, Jungang Wang, and Hong Shen. "Evaluation of the therapeutic effect of a fly maggot antimicrobial peptide in a Staphylococcus aureus-induced mouse mastitis model." Open Veterinary Journal 15 (2025), 2540-2550. doi:10.5455/OVJ.2025.v15.i6.26 MLA (The Modern Language Association) Style Wang, Zhengli, Jungang Wang, and Hong Shen. "Evaluation of the therapeutic effect of a fly maggot antimicrobial peptide in a Staphylococcus aureus-induced mouse mastitis model." Open Veterinary Journal 15.6 (2025), 2540-2550. Print. doi:10.5455/OVJ.2025.v15.i6.26 APA (American Psychological Association) Style Wang, Z., Wang, . J. & Shen, . H. (2025) Evaluation of the therapeutic effect of a fly maggot antimicrobial peptide in a Staphylococcus aureus-induced mouse mastitis model. Open Veterinary Journal, 15 (6), 2540-2550. doi:10.5455/OVJ.2025.v15.i6.26 |